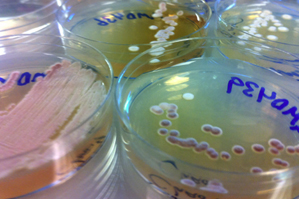

Sample America
Anthony D’Onofrio studies dirt…or the bacteria that grow on dirt, to be more specific. He is a post-doctoral researcher in the Antimicrobial Discovery Center led by Professor Kim Lewis in the biology department and has started a non-profit educational organization, along with Professor Lewis, called Sample America to help him with a somewhat impossible task: sifting through thousands of dirt and sand samples from across the continent, hoping to light on a novel antibiotic compound.
Anthony D’Onofrio studies dirt…or the bacteria that grow on dirt, to be more specific. He is a post-doctoral researcher in the Antimicrobial Discovery Center led by Professor Kim Lewis in the biology department and has started a non-profit educational organization, along with Professor Lewis, called Sample America to help him with a somewhat impossible task: sifting through thousands of dirt and sand samples from across the continent, hoping to light on a novel antibiotic compound.
Only one novel class of antibiotic has been discovered since 1962, when the field saw a surge in activity. The problem is, not all bacteria like to grow in the lab – the conditions just aren’t suitable for these finicky buggers. Luckily, Lewis and another biology professor, Slava Epstein, have figured out a few ways to coax them into growing on command.
With these new techniques in place, a flood of new bacteria are available for the finding and with them a slew of new antibiotics (bacteria produce antibiotics to kill off their neighbors). Thus, D’Onofrio has his work cut out for him.
So, what does anyone do when they have too big a job to manage alone? Enlist child labor of course. Well…not exactly. D’Onofrio has set up a non-profit organization that doesn’t just lighten his own load, but also gives high school and middle school students a chance to participate in real science with real significance.
Sample America provides classrooms with everything they need to grow bacteria from local soil samples and get a “resistance profile” of each by growing them in the presence of both common and rare antibiotics. Bacteria that are resistant to rare antibiotics are more likely to be resistant to other, yet undiscovered, antibiotics, which may be produced by the soil’s bacterial profile.
After getting the resistance profile, soil samples are sent back to Sample America where Lewis’s lab carries a drug discovery process to identify any new compounds.
It all boils down to a very lovely mission statement: “…Educating the scientists of tomorrow while finding cures for the world today.”





